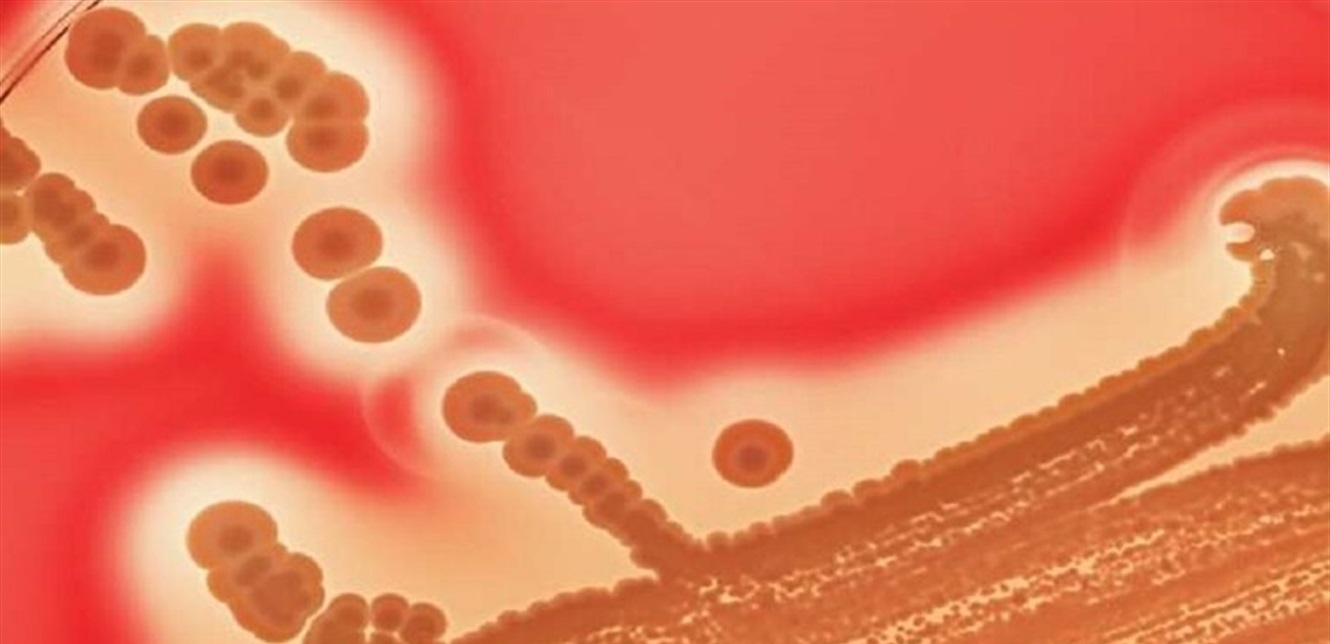

أفادت قناة NHK التلفزيونية اليابانية أن مرض “تآكل الجسم” ينتشر بسرعة في اليابان، وأنه يسبب وفاة ثلث المصابين بسبب نخر الأنسجة وفشل أعضاء الجسم.
وتسبب هذا المرض المكورات العقدية من المجموعة А، ولكن لم يحدد العلماء أسباب الزيادة في معدل الإصابات بعد، ولكنهم يشيرون إلى أن زيادة العدوى قد تكون مرتبطة برفع التدابير التقييدية التي تم تطبيقها خلال جائحة الفيروس التاجي المستجد.
ويوصي الخبراء للحماية من العدوى المحتملة بالاهتمام بالنظافة الشخصية وغسل اليدين بانتظام وارتداء الكمامات الواقية في الأماكن العامة. لأنه لم تدرس آلية الإصابة بالمرض الجديد، ولكنهم يعتقدون أن المكورات العنقودية يمكن أن تدخل إلى جسم الإنسان بسرعة من خلال الجروح.
ووفقا لبيانات المعهد الوطني الياباني للأمراض المعدية، بلغ عدد المصابين بهذا المرض منذ بداية عام 2024 وحتى 5 أيار 801 أي ما يزيد بمقدار 2.76 مرة مقارنة بنفس الفترة من عام 2023. (RT)

اترك ردك